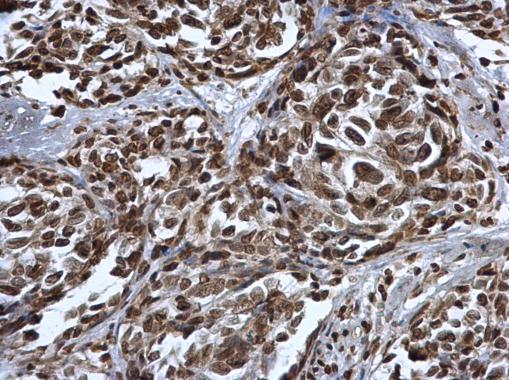
产品封面图

相关产品推荐更多 >
万千商家帮你免费找货
0 人在求购买到急需产品
- 详细信息
- 文献和实验
- 技术资料
- 免疫原:
Carrier-protein conjugated synthetic peptide surrounding mono-methyl Lys372 of human p53. The exact sequence is proprietary.
- 亚型:
IgG
- 形态:
Liquid
- 保存条件:
Store as concentrated solution. Centrifuge briefly prior to opening vial. For short-term storage (1-2 weeks), store at 4ºC. For long-term storage, aliquot and store at -20ºC or below. Avoid multiple freeze-thaw cycles.
- 克隆性:
Polyclonal
- 标记物:
Unconjugated
- 适应物种:
Human, Frog, Squirrel
- 保质期:
12 months from the shipping date of the product.
- 抗原来源:
Human
- 目录编号:
GTX117515
- 级别:
Primary Antibodies
- 库存:
Available
- 供应商:
GeneTex
- 宿主:
Rabbit
- 应用范围:
WB, ICC/IF, IHC-P
- 浓度:
1.43 mg/ml (Please refer to the vial label for the specific concentration.)
- 靶点:
p53 (mono-methyl Lys372)
- 抗体英文名:
p53 (mono-methyl Lys372) antibody
- 抗体名:
p53 (mono-methyl Lys372) 抗体
- 规格:
100 μl/25 μl
| 规格: | 100 μl | 产品价格: | ¥4000.0 |
|---|---|---|---|
| 规格: | 25 μl | 产品价格: | ¥1700.0 |

p53 (mono-methyl Lys372) antibody detects p53 (mono-methyl Lys372) protein at nucleus and endoplasmic reticulum by immunofluorescent analysis.
Sample: Mock and treated HCT116 cells were fixed in 4% PFA at RT for 15 min.
Green: p53 (mono-methyl Lys372) stained by p53 (mono-methyl Lys372) antibody (GTX117515) diluted at 1:500.
Blue: Fluoroshield with DAPI (GTX30920).

Confocal immunofluorescence analysis (Olympus FV10i) of PFA-fixed U2OS, using p53 (mono-methyl Lys372)(GTX117515) antibody (Green) at 1:500 dilution. Alpha-tubulin filaments were labeled with GTX11304 (Red) at 1:2000.

p53 (mono-methyl Lys372) antibody detects p53 (mono-methyl Lys372) protein at cytoplasm and nucleus in human cervical cancer by immunohistochemical analysis.
Sample: Paraffin-embedded human cervical cancer.
p53 (mono-methyl Lys372) antibody (GTX117515) diluted at 1:500.
Antigen Retrieval: Citrate buffer, pH 6.0, 15 min

Untreated (–) and treated (+) HCT-116 whole cell extracts (30 μg) were separated by 10% SDS-PAGE, and the membrane was blotted with p53 (mono-methyl Lys372) antibody (GTX117515) diluted at 1:500. The HRP-conjugated anti-rabbit IgG antibody (GTX213110-01) was used to detect the primary antibody.
风险提示:丁香通仅作为第三方平台,为商家信息发布提供平台空间。用户咨询产品时请注意保护个人信息及财产安全,合理判断,谨慎选购商品,商家和用户对交易行为负责。对于医疗器械类产品,请先查证核实企业经营资质和医疗器械产品注册证情况。
 文献和实验
文献和实验Watts AJ et al., J Exp Zool A Ecol Integr Physiol 2019 (PMID:30767414)
Hawkins LJ et al., J Comp Physiol B 2017 (PMID:28601897)
Methyl DNA Immunoprecipitation
can be done. This methylation analysis is highly specific due to the use of a well-characterized monoclonal antibody and each IP is directly quality controlled: two essential keys for reliable results. In addition, the kit protocol is fast and user-friendly. The METHYL kit
【求助】P53的翻译后修饰都有哪些? 怎样验证其修饰后与靶标启动子的结合活性的变化?
细胞中MDM2是调解p53含量的主要的泛素连接酶,MDM2 结合至p53的N-末端区域,并通过两种机制来抑制p53的活性:一是促进p53输出至胞质并降解;二是阻断p53的转录激活。活化的p53可以上调MDM2,并因此产生了p53-MDM2的自身调节回路。DNA损伤可以导致MDM2稳定性的下降并促进其降解,限制应激反应中p53与MDM2的相互作用,从而保持了p53的活性并减少了其降解 [26]。 甲基化修饰 P53的Lys372残基可以被SET9(SET区域含有的蛋白
Technovit® 9100 Methyl Methacrylate
in this leaflet. They are analogous to those used with methyl methacrylate (MMA) thin sections. Routine Staining Counterstaining of Sections for Immuno- and Enzyme-lmmunohistochemistry Haematoxylin according to Mayer
 技术资料
技术资料暂无技术资料 索取技术资料

![EMR2 antibody [2A1]](https://img1.dxycdn.com/2022/0328/445/8145928122501400453-14.jpg!wh200)

![CD59 antibody [MEM-43] (APC)](https://img1.dxycdn.com/2022/0328/801/2871272636095500453-14.jpg!wh200)
![EGFR (phospho Tyr1068) antibody [Y38]](https://img1.dxycdn.com/2022/0329/854/5425390049155020453-14.jpg!wh200)

